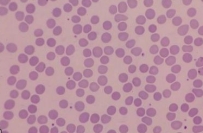
<p>What type of blood cells are these?</p>

Block 4 ALS Revision Questions
1/164
There's no tags or description
Looks like no tags are added yet.
Name | Mastery | Learn | Test | Matching | Spaced | Call with Kai |
|---|
No analytics yet
Send a link to your students to track their progress
165 Terms
What are the main innate immunity cells?
Neutrophils
Monocytes
Natural killer cells
Mast cells
Basophils
Eosinophils
What cells give rise to platelets, erythrocytes and monocytes?
Haematopoietic stem cells
Where is the primary site of haematopoiesis in a foetus?
Liver
What are the main growth factors that regulate haematopoiesis?
Interleukins 1-3
Stem cell factor
Erythropoietin
What are the four components of an erythrocyte membrane?
Spectrin
Ankyrin
Band 4.1 protein
Band 3 protein
What is the function of spectrin in the erythrocyte membrane?
Forms scaffold that maintains integrity and shape of membrane
What is the function of ankyrin in the erythrocyte membrane?
Anchors ion channels to spectrin skeleton
What is the function of band 4.1 protein in the erythrocyte membrane?
Regulates membrane stability by stabilising spectrin-actin cytoskeleton
What is the function of band 3 protein in the erythrocyte membrane?
Exchanges chloride and bicarbonate ions across the membrane
What type of blood cells are these?
Erythrocytes
Biconcave with no nucleus
Where are damaged erythrocytes removed from the blood?
Spleen
What class of antigens determine the blood type of a person?
ABO antigens
Split into A and B
What are the eight blood types?
A+, A-, B+, B-, O+, O-, AB+, AB-

What antibodies target non-present ABO antigens?
IgM
What is haematocrit?
The percentage volume of erythrocytes in the blood
What are the normal haematocrit levels?
Female - 40%
Male - 45%
What are platelets derived from?
Megakaryocytes
What regulates platelet production?
Thrombopoietin
What is the primary function of platelets?
Aggregation at site of wound repair to stop bleeding
What clotting components are required for platelet aggregation?
von Willebrand factor
Fibrinogen
What are the three types of granules found in platelets?
Dense
Lambda
Alpha
What is the function of dense granules in platelets?
Stimulate aggregation
Contain ATP, calcium and 5-HT
What is the function of lambda granules in platelets?
Contain hydrolytic enzymes
What is the function of alpha granules in platelets?
Contain coagulation factors
What are the four types of phagocyte?
Neutrophils
Eosinophils
Basophils
Monocytes
What do neutrophils induce?
Inflammatory response
What is microcytic anaemia?
Form of anaemia marked by erythrocytes with a MCV < 80 fL
What is iron deficiency anaemia?
Anaemia caused by inadequate absorption of iron
Indicated by a low haemoglobin
What is thalassaemia?
Deficient synthesis of haemoglobin
Genetic condition
What is aplastic anaemia?
Anaemia caused by damage to bone marrow
What is the normal structure of haemoglobin?
Globin ring of 4 polypeptide chains - 2 alpha, 2 beta
Haem ring with Fe2+ ion in centre
How does foetal haemoglobin differ from adult haemoglobin?
2 gamma chains in place of 2 beta chains
What is indicated by a rise in HbA2?
Sickle cell anaemia
What are the three main forms of beta thalassaemia?
Minor - mild or absent anaemia
Intermedia - moderate anaemia
Major - severe anaemia requiring regular transfusions
What is the lifecycle of erythrocytes?
Damaged RBCs removed from circulation by macrophages in spleen, liver and red bone marrow
Globin and haem are split and globin further broken down into amino acids
Iron is removed from haem in the form of Fe3+ associated with transferrin
In the spleen, liver and muscle fibres Fe3+ detaches from transferrin and binds to ferritin
At the storage site Fe3+ is released from ferritin and reattaches to transferrin
This complex is transported to the red bone marrow
RBC precursor cells take up the complex by receptor-mediated endocytosis and use Fe3+ to form haem and globin is produced from amino acids
RBCs are produced in the red bone marrow by erythropoiesis
The non-iron portion of old haem is converted into biliverdin and then bilirubin and enters the blood
Bilirubin is transported to hepatocytes and placed in the bile where it is released into the small intestine
Bilirubin is converted into urobilinogen and some is reabsorbed and excreted in urine as urobilin, with the majority converted to stercobilin and excreted in faeces
What is the precursor for erythrocytes?
Reticulocytes
What do proerythroblasts divide into?
Haemoglobin synthesising cells
What is polycythaemia?
Excess of red blood cells in production
Absolute - overproduction of red blood cells
Primary - due to neoplastic proliferation of haematopoietic cells in the bone marrow
Secondary - due to increased erythropoietin, e.g. in hypoxia
Relative - apparent rise in red blood cells, actually due to reduction in blood plasma
What are the clinical signs of polycythaemia?
Breathing difficulties
Dizziness
Excessive bleeding
Splenomegaly
Headache
What is the difference between primary and secondary polycythaemia?
Primary - genetic problem resulting in excess production of erythrocytes
Secondary - due to conditions that promote erythrocyte development
What is relative polycythaemia?
Normal red blood cell levels but reduced plasma volume, e.g. due to dehydration
What is essential thrombocythaemia?
Overproduction of platelets by megakaryocytes
What is thrombocytopenia?
Decreased platelet levels
What blood disorders are associated with mutations in the JAK2 gene?
Polycythaemia vera
Essential thrombocythaemia
What causes primary immunodeficiency?
Chronic granulomatous diseases
What causes secondary immunodeficiency?
Viral diseases, e.g. HIV/AIDS
What is autoinflammation?
Prolonged, unwanted innate immunity
What is autoimmunity?
Loss or failure of self recognition
What is the principle site of haematopoiesis in adults?
Long bones
What are primary lymphoid tissues?
Sites where lymphocytes differentiate to express antigen receptors
e.g. thymus and bone marrow
What are secondary lymphoid tissues?
Specialised sites for turning on the acquired immune response
e.g. lymph nodes, spleen, mucosal associated lymphoid tissue (MALT)
What do superficial lymphatics follow?
Superficial veins
What do deep lymphatics follow?
Main vessels, e.g. aorta
Where does the majority (3/4) of lymph from the body drain into?
Left brachiocephalic vein via the thoracic duct
Where does lymph from the upper right quadrant drain into?
Right brachiocephalic vein
What do lymph nodes represent?
Anatomical meeting place for cells of the immune system and their exposure to antigens
Where in a lymph node do B cells circulate?
Follicles
Where in a lymph node are T cells found?
Periarteriolar region
What is the largest lymphoid organ?
Spleen
What are the main functions of the spleen?
Direct immune response to antigens in blood
Clearance of old or damaged red blood cells
What is the role of haemostasis?
Limitation of blood loss
Removal of damaged tissue
Re-growth and repair of tissue
What are the four haemostatic components?
Vascular system
Coagulation proteins
Platelets
Fibrinolytic system and coagulation inhibitors
What are the three pathways of the coagulation cascade?
Extrinsic
Intrinsic
Common
What is haemangioblasts?
Stem cells within the blood vessel that give rise to endothelial and haematopoietic cells
Exist in tunica intima
What is the extrinsic pathway?
Tissue trauma
Tissue factor leaks into blood from cells outside vessels
Presence of Ca2+ results in TF activating factor X
Activating factor X combines with factor V in presence of Ca2+ to form active enzyme prothrombinase
How fast is the extrinsic pathway?
Very fast - can occur in seconds if trauma is severe enough
What is the intrinsic pathway?
Damage to endothelial cells exposes collagen fibres and blood comes into with them
This also damages platelets which release phospholipids
Blood contact with collagen activates factor XII
Factor XII in presence of Ca2+ and platelet phospholipids eventually activates factor X
Activated factor X combines with factor V in presence of Ca2+ to form active enzyme prothrombinase
What marks the beginning of common pathway?
Formation of prothrombinase
What is the common pathway?
Prothrombinase and Ca2+ catalyse conversion of prothrombin to thrombin
Thrombin converts soluble fibrinogen to insoluble loose fibrin strands
Thrombin also activates factor XIII
Factor XIII strengthens and stabilises fibrin strands into a clot
What is clot retraction?
Consolidation or tightening of fibrin clot
What do natural killer cells attack?
Any body cells displaying abnormal or unusual plasma membrane proteins
What is the role of perforin?
Inserted into plasma membrane of infected cell and creates channels
Extracellular matrix enters cell and causes it to burst in cytolysis
What are granzymes?
Protein-digesting enzymes that induce apoptosis in target cells
What are the two main phagocytes?
Neutrophils
Macrophages
What is the difference between wandering and fixed macrophages?
Wandering - actively phagocytic, move around the body
Fixed - stay in specific tissue
What are the five stages of phagocytosis?
Chemotaxis
Adherence
Ingestion
Digestion
Killing
What is the process of chemotaxis in phagocytosis?
Chemically stimulated movement of phagocytes to site of damage
What is the process of adherence in phagocytosis?
Attachment of phagocyte to microbe or other foreign material
What is the process of ingestion in phagocytosis?
Phagocyte extends pseudopods and engulfs microbe
Microbe is eventually surrounded by phagosome
What is the process of digestion in phagocytosis?
Phagosome enters cytoplasm and merges with lysosomes to form phagolysosome
Lysozyme is secreted to break down cell wall, along with other compounds to degrade microbe
What is the process of killing in phagocytosis?
Microbe killed
Remaining structures kept in residual bodies
What are the characteristic symptoms of inflammation?
Redness
Pain
Heat
Swelling
Loss of function
What are the two immediate changes in blood vessels in the region of tissue injury?
Vasodilation - allows greater blood flow to area
Increased permeability - allows defensive proteins (antibodies, clotting factors) to enter injured area from the blood
What are the five substances that contribute to the inflammatory response?
Histamine
Kinins
Prostaglandins
Leukotrienes
Complements
What is the effect of histamine in the inflammatory response?
Vasodilation and increased permeability of blood vessels
What is the effect of kinins in the inflammatory response?
Induce vasodilation and increased permeability
Chemotactic agents for phagocytes
What is the effect of prostaglandins in the inflammatory response?
Intensify effects of histamine and kinins
Stimulate emigration of phagocytes through capillary walls
What is the effect of leukotrienes in the inflammatory response?
Increase permeability
Chemotactic agents
Enhance adherence of phagocytes to pathogens
What is the effect of complements in the inflammatory response?
Stimulate histamine release
Chemotactic agents
Promote phagocytosis
What are the three stages of inflammation?
Vasodilation and increased permeability
Phagocyte emigration
Tissue repair
Where do B cells form and mature?
Bone marrow
Where do T cells form and mature?
Form - bone marrow
Mature - thymus
What is immunocompetence?
Ability to carry out immune responses
What are the two types of T cell?
Helper T cells - CD4
Cytotoxic T cells - CD8
What are the two types of adaptive immunity?
Cell-mediated
Antibody-mediated
What is clonal selection?
Proliferation and differentiation of a lymphocyte in response to a specific antigen
What is antigen processing?
Breakdown of antigenic proteins into peptide fragments that associate with MHC molecules
What do MHC class 1 molecules process?
Endogenous antigens, e.g. viral, intracellular bacterial
What do MHC class 2 molecules process?
Exogenous antigens, e.g. bacteria, parasiticl
When do T cells ignore an antigen-MHC complex?
When the peptide fragment is from a self-protein